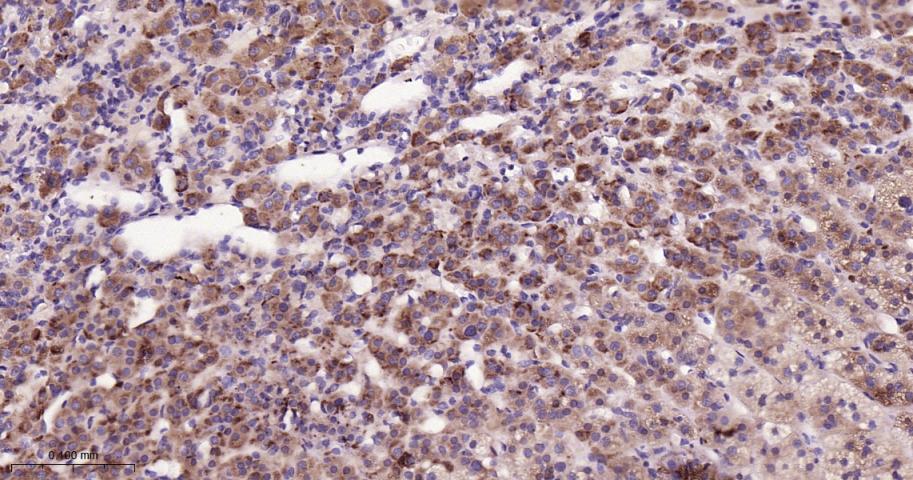
脂肪分化相关蛋白重组兔单抗

脂肪分化相关蛋白重组兔单抗
Rrmab?兔单抗

货号:bsm-54764R
产品详情
相关标记
相关产品
相关文献
常见问题
概述
产品编号
bsm-54764R
产品类型
重组兔单抗、mIHC精品抗体
英文名称
PLIN2 Recombinant Rabbit mAb
中文名称
脂肪分化相关蛋白重组兔单抗
英文别名
ADFP; ADRP; ADPH; PLIN2_HUMAN; PLIN2; Adipophilin; Adipose differentiation-related protein (ADRP); PLIN2_MOUSE;
抗体来源
Rabbit
免疫原
A synthesized peptide derived from human Perilipin 2: 1-69
亚型
IgG
性状
Liquid
纯化方法
affinity purified by Protein A
克隆类型
Recombinant
克隆号
7B2
理论分子量
48 kDa
浓度
1mg/ml
储存液
0.01M TBS (pH7.4) with 1% BSA, 0.02% Proclin300 and 50% Glycerol.
SWISS
Gene ID
保存条件
Shipped at 4℃. Store at -20℃ for one year. Avoid repeated freeze/thaw cycles.
注意事项
This product as supplied is intended for research use only, not for use in human, therapeutic or diagnostic applications.
数据库链接
产品介绍
Adipophilin(ADFP)是一种脂滴周围主要的相关蛋白,它大量分布在脂质蓄积正常或不正常的细胞中,是脂质蓄积的一个特异性标记物。它在脂肪细胞分化早期就有很高的表达,但当脂肪细胞成熟后,它的表达就明显减少,故称;脂肪分化相关蛋白。
ADFP在很多组织器官中都发挥重要作用,它不仅参与脂肪细胞的脂质代谢、脂滴的形成及肝内三酰甘油(TO)的合成与代谢,还能促进巨噬细胞、平滑肌细胞的泡沫化,长链脂肪酸的摄取,乳汁的分泌等。
ADFP的表达异常与动脉粥样硬化、胰岛素抵抗和肿瘤等病理过程密切相关。
背景资料
The protein encoded by this gene belongs to the perilipin family, members of which coat intracellular lipid storage droplets. This protein is associated with the lipid globule surface membrane material, and maybe involved in development and maintenance of adipose tissue. However, it is not restricted to adipocytes as previously thought, but is found in a wide range of cultured cell lines, including fibroblasts, endothelial and epithelial cells, and tissues, such as lactating mammary gland, adrenal cortex, Sertoli and Leydig cells, and hepatocytes in alcoholic liver cirrhosis, suggesting that it may serve as a marker of lipid accumulation in diverse cell types and diseases. Alternatively spliced transcript variants have been found for this gene. [provided by RefSeq, Mar 2011]

产品应用
| 应用 | 已检合格种属 | 预测种属 | 推荐稀释比例 |
|---|---|---|---|
| WB | Human | Mouse, Rat | 1:500-2000 |
| IHC-P | Human, Mouse, Rat | 1:100-500 | |
| IHC-F | Human, Mouse, Rat | 1:100-500 | |
| IF | Human, Mouse, Rat | 1:100-500 | |
| Flow-Cyt | Human | Mouse, Rat | 1:50-100 |
交叉反应
交叉反应: Human, Mouse, Rat
相关产品
暂无相关产品
靶标
基因名
PLIN2
蛋白名
Perilipin-2
亚细胞定位
Membrane; Peripheral membrane protein.
组织特异性
Milk lipid globules.
翻译后修饰
Acylated; primarily with C14, C16 and C18 fatty acids.
相似性
Belongs to the perilipin family.
功能
May be involved in development and maintenance of adipose tissue.
标记抗体
暂无标记数据
同靶标产品
暂无同靶标产品
相关文献
提示: 发表研究结果有使用 bsm-54764R 时请让我们知道,以便我们可以引用参考文章。作为回馈,资料提供者将获得我们送上的小礼品。
暂无相关文献
常见问题
暂无常见问题